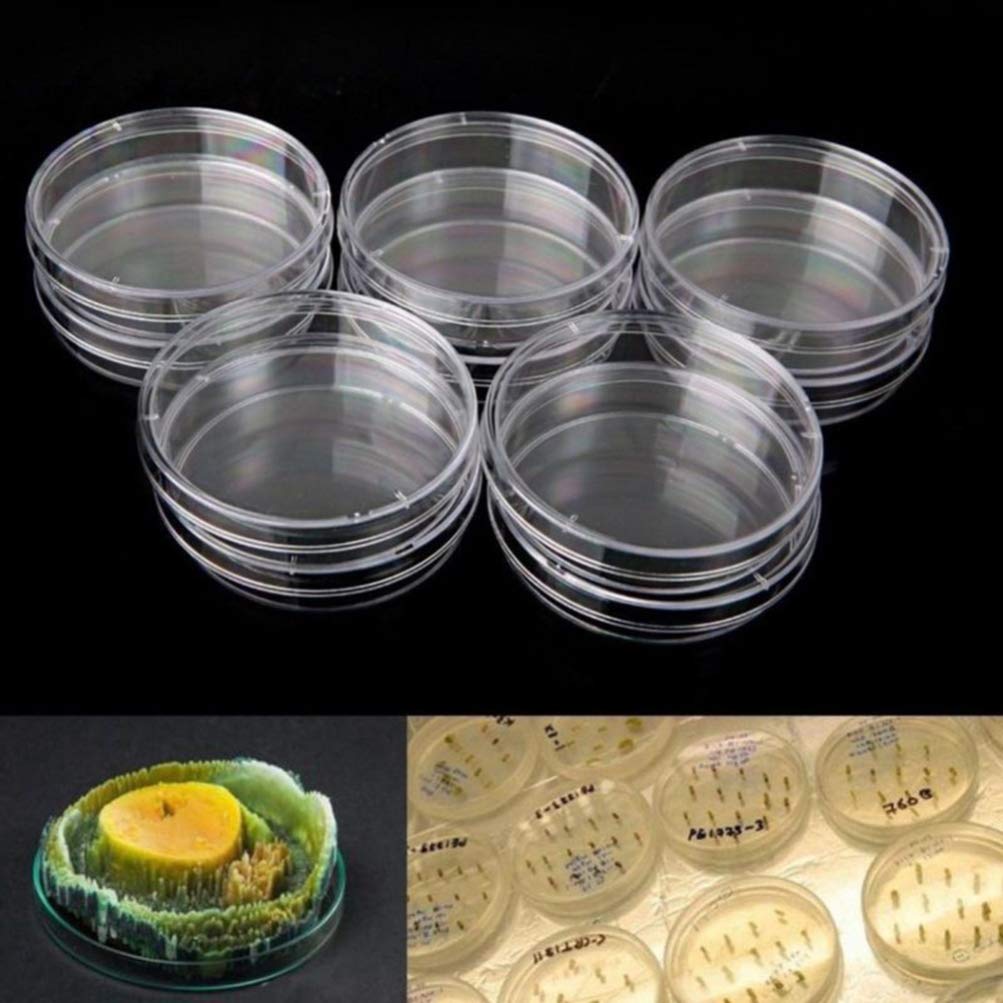
Thumbnail 3

🔍 Elevate your experiments with precision and style!
These Generic Petri Dishes are engineered for durability and versatility, making them perfect for laboratory science projects at home or school. With high-temperature resistance and eco-friendly reusability, they are designed to support a variety of cultivation needs, from plant materials to microorganisms.
| Manufacturer | Generic |
| Part number | EPVVPZIY3EAR0566J17A06 |
| Item Weight | 450 g |
| Product Dimensions | 10 x 10 x 10 cm; 450 g |
| Item model number | EPVVPZIY3EAR0566J17A06 |
| Item Package Quantity | 1 |
| Batteries Required? | No |
Trustpilot
2 weeks ago
1 week ago